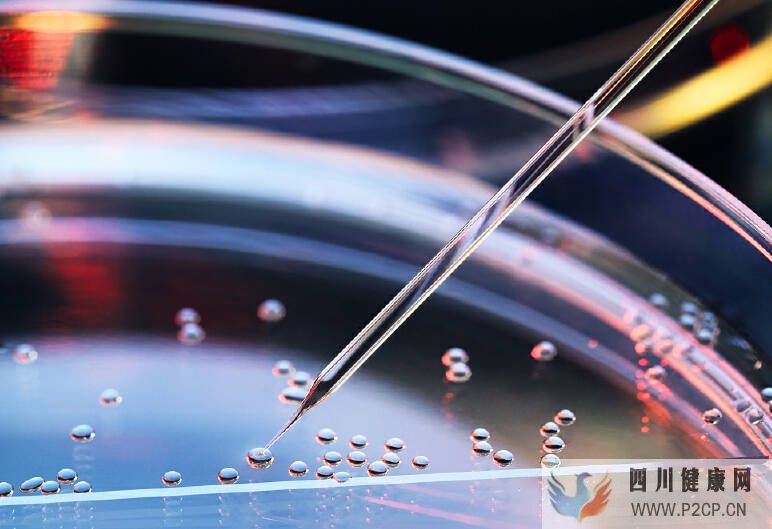
干细胞对什么病症有治疗作用?(干细胞的治疗作用)(图1) 干细胞对什么病症有治疗作用?(干细胞的治疗作用)(图1)

干细胞对什么病症有治疗作用?(干细胞的治疗作用)
原标题:干细胞对什么病症有治疗作用?
干细胞是人体最重要的细胞,被誉为人类再生的奇迹,因为干细胞具有高度活性,能够支持造血功能和补充免疫力,因此,现代医学技术经常利用干细胞来治疗一些疑难杂症,让越来越多的人获得健康的身体,其中,干细胞疗法的作用最为突出。
干细胞是一种具有自我更新能力和多向分化潜能的原始细胞,是机体的起源细胞,在一定条件下,可以分化成多种功能细胞或组织器官,因此可以成为万能细胞。干细胞疗法是通过对干细胞进行体外分离、培养、定向诱导分化等,培养出一种全新的、正常的、更年轻的细胞、组织甚至微型器官等,再移植到人体内的特定部位和器官,代替那些受损或非正常死亡的细胞,从而恢复机体功能。
通俗来讲,干细胞就像是生命的种子,是一种可以自我更新和再生的多功能细胞。在一定条件下,可分化成多种功能细胞,具有修复各种组织功能和再生器官的能力,被医学界称为“万能细胞”。
心脏病
修复受损的心脏组织
目标:利用干细胞修复心脏病发作时受损的心脏组织。
功效:干细胞具有心脏组织分化能力,可诱导、促进干细胞向心脏靶向归巢,将干细胞整合至损伤心肌,促进心脏前体细胞的分化,进而提高心脏自我修复潜力。
生长心血管
目标:血管新生——促进新生血管的生长。
功效:几种不同来源的包括牙髓干细胞在内的干细胞,已经被证明能刺激毛细血管的生长。
角膜疾病
目标:利用干细胞改善角膜病患者的视力。
功效:英国的一项研究得出了结论,干细胞是“一种能够重建角膜表面并恢复患者视力”的安全有效的方法。
黄斑病症
目标:使用干细胞制造专门的细胞来帮助治疗黄斑营养不良和干性黄斑变性。
功效:干细胞治疗黄斑病症的这项测试正处于初期阶段,目前已经报道2例患者的治疗结果,均未出现治疗副作用。
糖尿病
目标:利用干细胞来治疗2型糖尿病。
功效:将提取的干细胞进行体外分离、纯化、扩增后,回输到糖尿病患者体内,干细胞就会像种子一样在胰腺组织微环境的诱导下分化增殖为胰岛细胞,替代受损的胰岛β细胞,分泌胰岛素,促进受损胰岛组织细胞的再生、修复,从而起到从根本上治疗糖尿病的作用。
大量的治疗案例显示,利用干细胞治疗后不会产生并发症和副作用,且可以提高身体免疫力,甚至可使患者摆脱终身打针服药。
脑卒中
目标:用干细胞来抵消中风造成的脑损伤,修复脑卒中受损区域的组织,并逆转中风导致的残疾。
功效:利用干细胞,可使脑部功能更年轻化。
干细胞回输人体后可分化形成新的神经细胞,为大脑提供全新细胞源,能有效改善脑衰老状况,尤其对老年性痴呆患者的记忆力、智力,有明显改善和恢复。
脊髓损伤
目标:使用干细胞治疗患有不同程度瘫痪患者的慢性脊髓损伤。
功效:干细胞在体内或体外特定的诱导条件下,可分化为骨、软骨、肌肉、肌腱、韧带、神经等多种组织细胞,作为种子细胞可用于组织器官的损伤修复。
2009年,医学院的科学家发表了一项涉及39名慢性脊髓损伤患者的研究。他们将干细胞回输至患者腿部的股动脉,随后研究人员表示该疗法是安全的,26名患者(66%)的刺激反应有所改善。
帕金森病
目标:利用干细胞干预治疗和控制帕金森病的发展,提高患者的生活质量。
功效:干细胞被认为是十分有效的帕金森治疗方法。干细胞具有自我更新以及可分化成任何类型神经细胞的能力,如分化成为神经元和神经胶质细胞,具有挽救功能失调神经通路的能力。
中国科学家近期在《STEM CELLS》杂志上揭示,干细胞治疗有助于通过刺激室管膜下区(SVZ)干细胞产生更多的神经细胞,以达到治疗帕金森病的目的。
干细胞移植治疗,是一门先进的医学技术,为一些疑难杂症的治疗带来了希望。干细胞移植治疗是把健康的干细胞移植到患者体内,以达到修复或替换受损细胞或组织,从而达到治愈的目的。干细胞移植治疗范围很广,一般能治疗神经系统疾病、免疫系统疾病、还有其他的一些内外科疾病。返回搜狐,查看更多
责任编辑:





